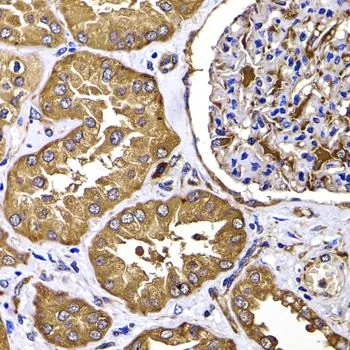

IHC-P analysis of human kidney tissue using GTX55815 PIMT antibody. Dilution : 1:100
PIMT antibody
GTX55815
ApplicationsWestern Blot, ImmunoHistoChemistry, ImmunoHistoChemistry Paraffin
Product group Antibodies
ReactivityHuman, Mouse
TargetTGS1
Overview
- SupplierGeneTex
- Product NamePIMT antibody
- Delivery Days Customer9
- Application Supplier NoteWB: 1:500 - 1:2000. IHC-P: 1:50 - 1:200. *Optimal dilutions/concentrations should be determined by the researcher.Not tested in other applications.
- ApplicationsWestern Blot, ImmunoHistoChemistry, ImmunoHistoChemistry Paraffin
- CertificationResearch Use Only
- ClonalityPolyclonal
- ConjugateUnconjugated
- Gene ID96764
- Target nameTGS1
- Target descriptiontrimethylguanosine synthase 1
- Target synonymsNCOA6IP, PIMT, PIPMT, trimethylguanosine synthase, CLL-associated antigen KW-2, PRIP-interacting protein with methyltransferase motif, cap-specific guanine-N(2) methyltransferase, cap-specific guanine-N2 methyltransferase, hepatocellular carcinoma-associated antigen 137, nuclear receptor coactivator 6-interacting protein
- HostRabbit
- IsotypeIgG
- Protein IDQ96RS0
- Protein NameTrimethylguanosine synthase
- ReactivityHuman, Mouse
- Storage Instruction-20°C or -80°C,2°C to 8°C
- UNSPSC12352203






